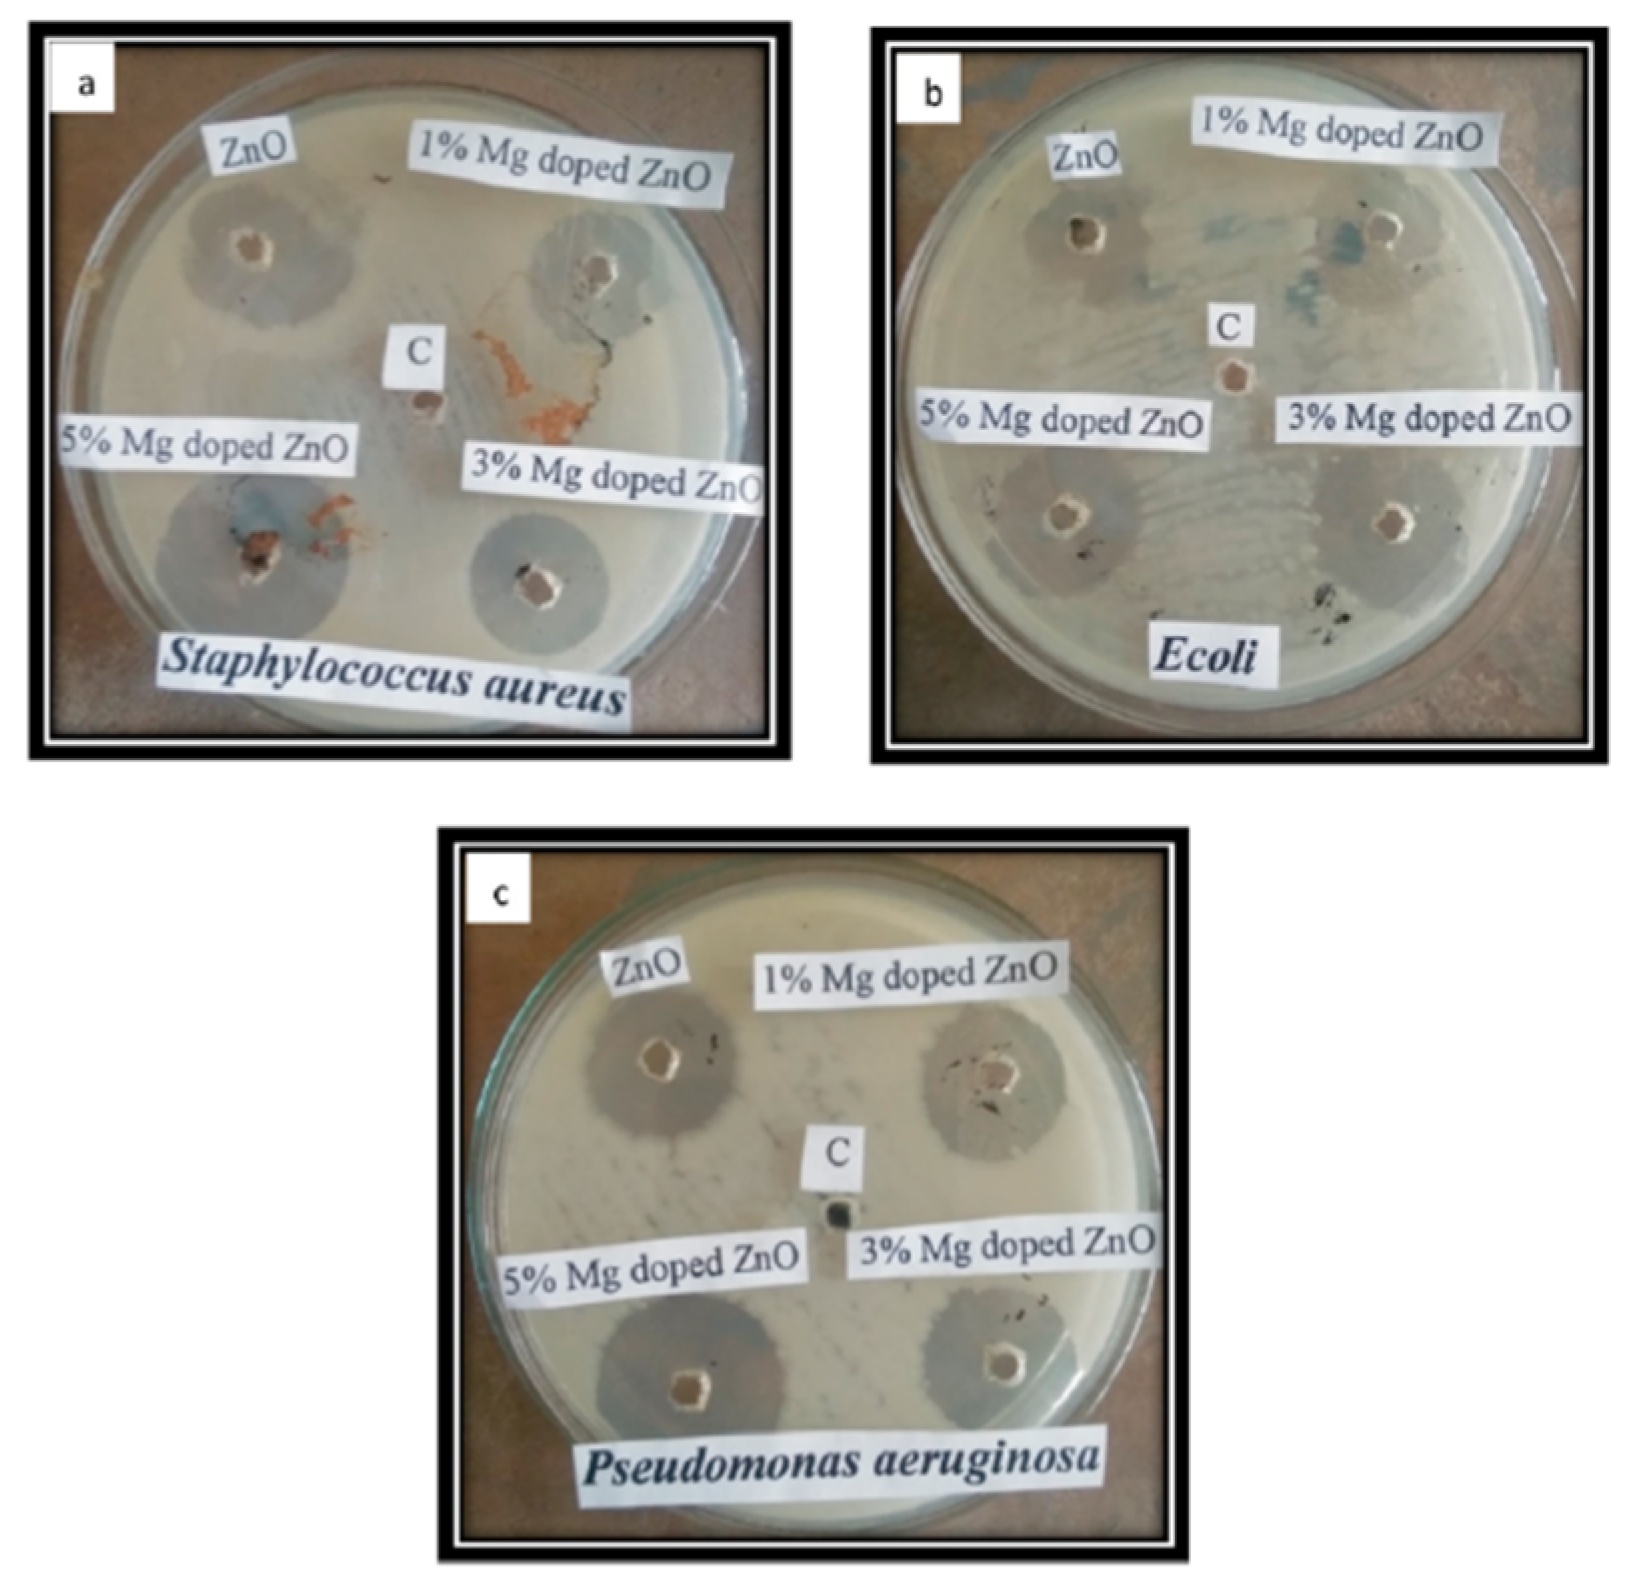
Applsci 12 07910 g015
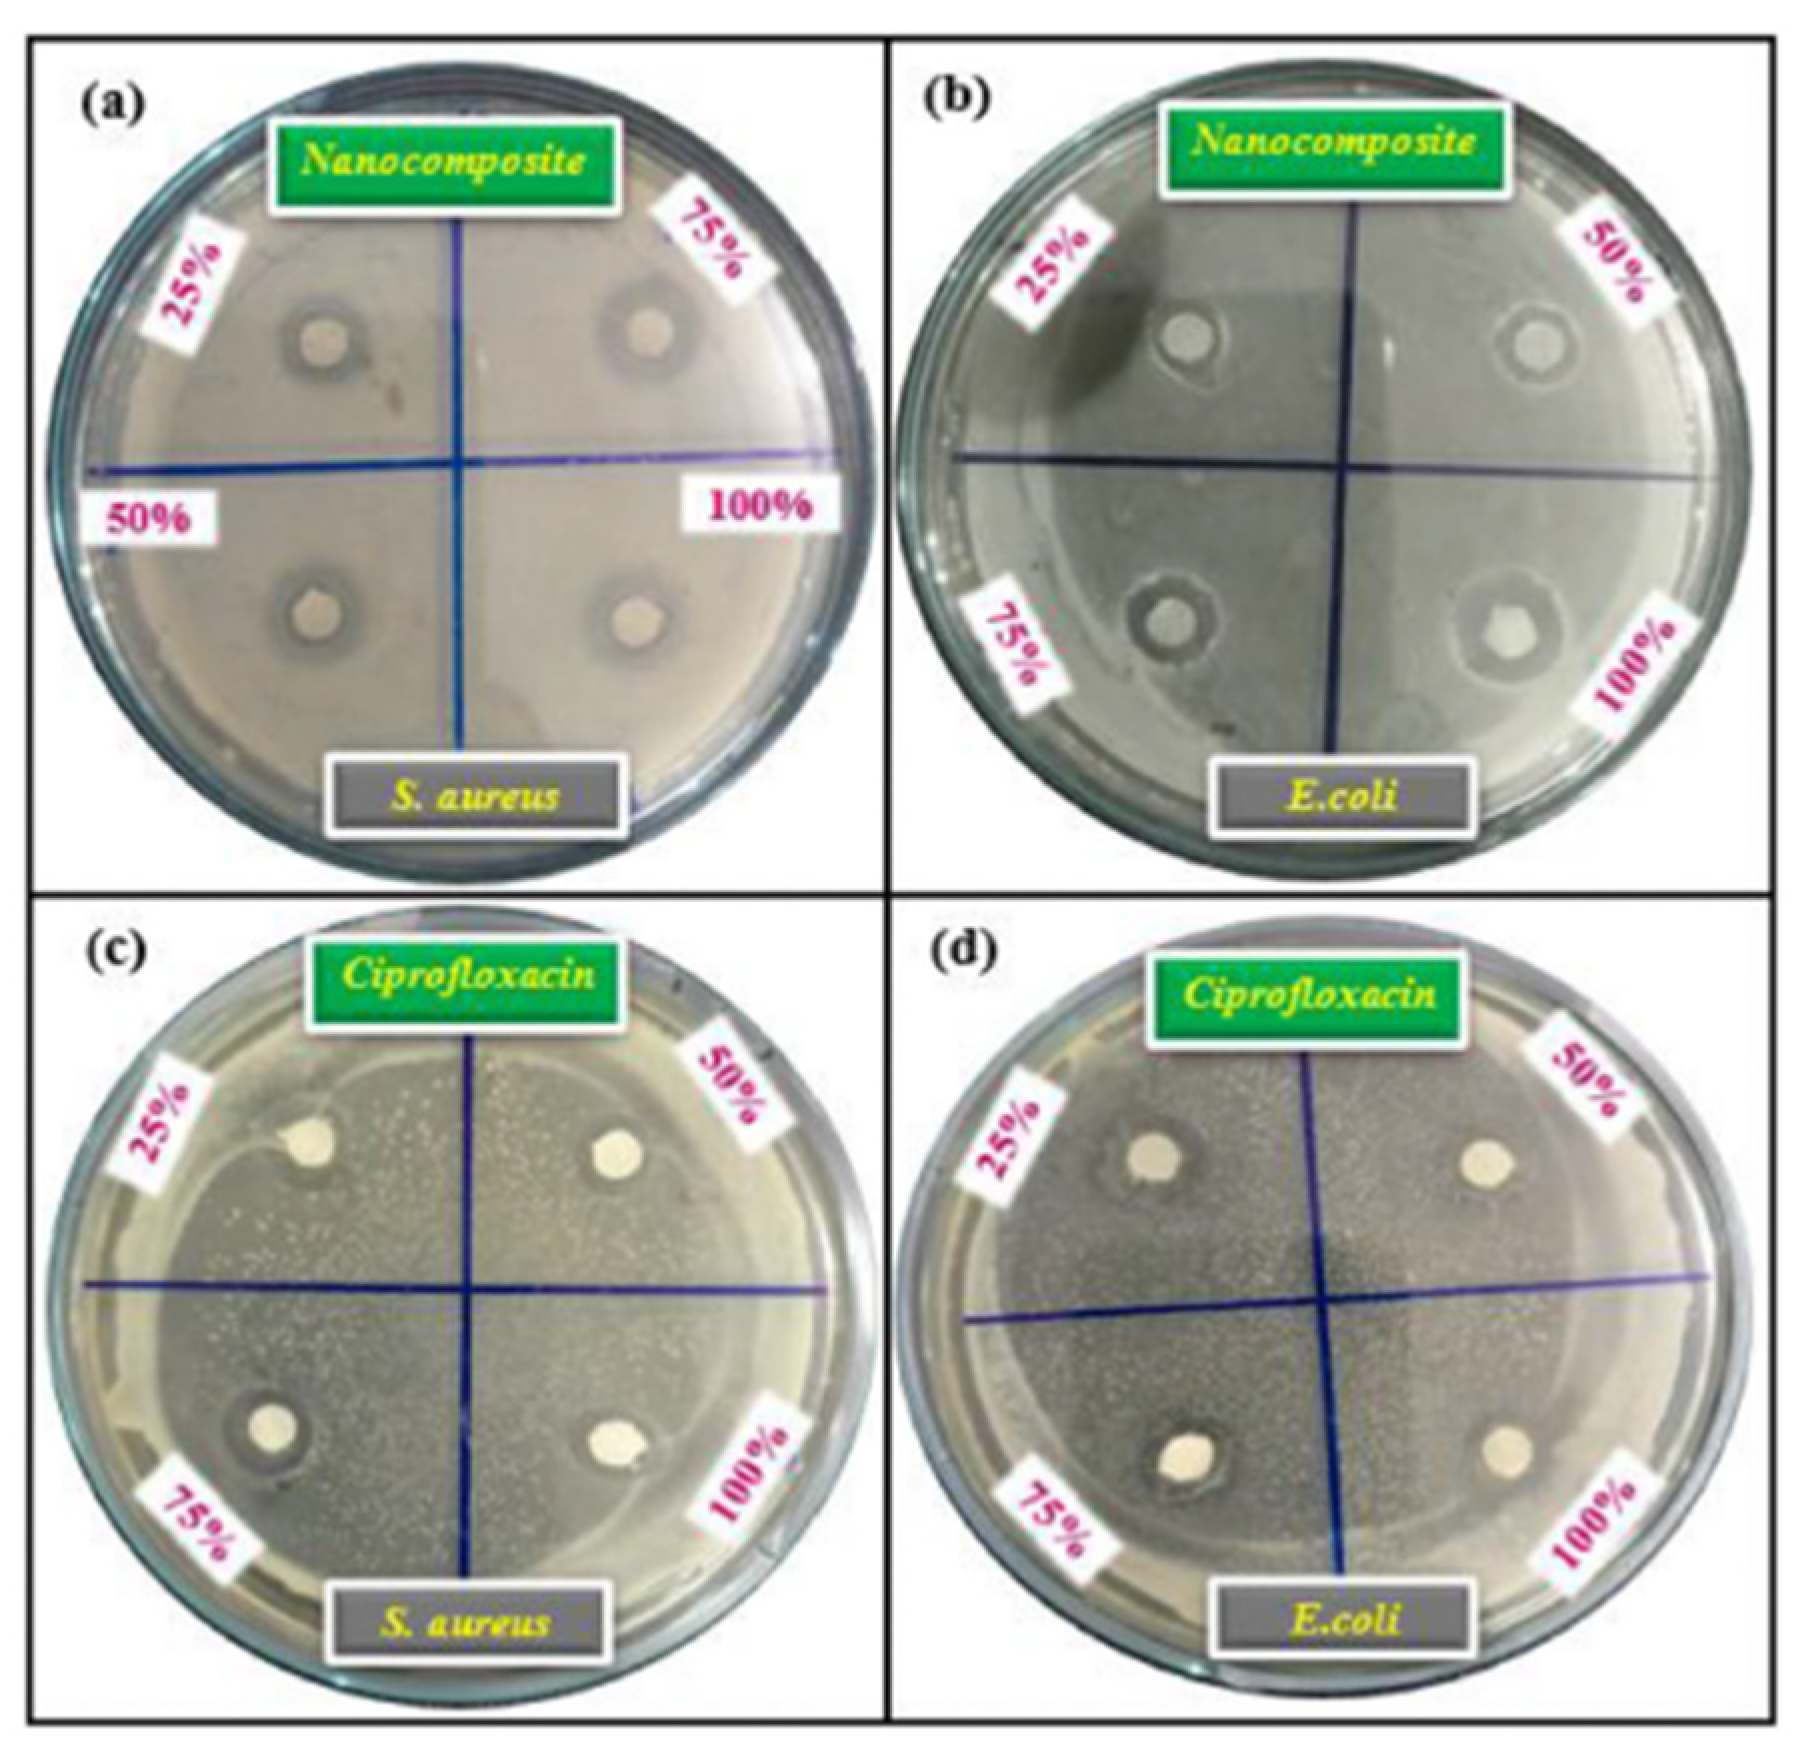
Applsci 12 07910 g020
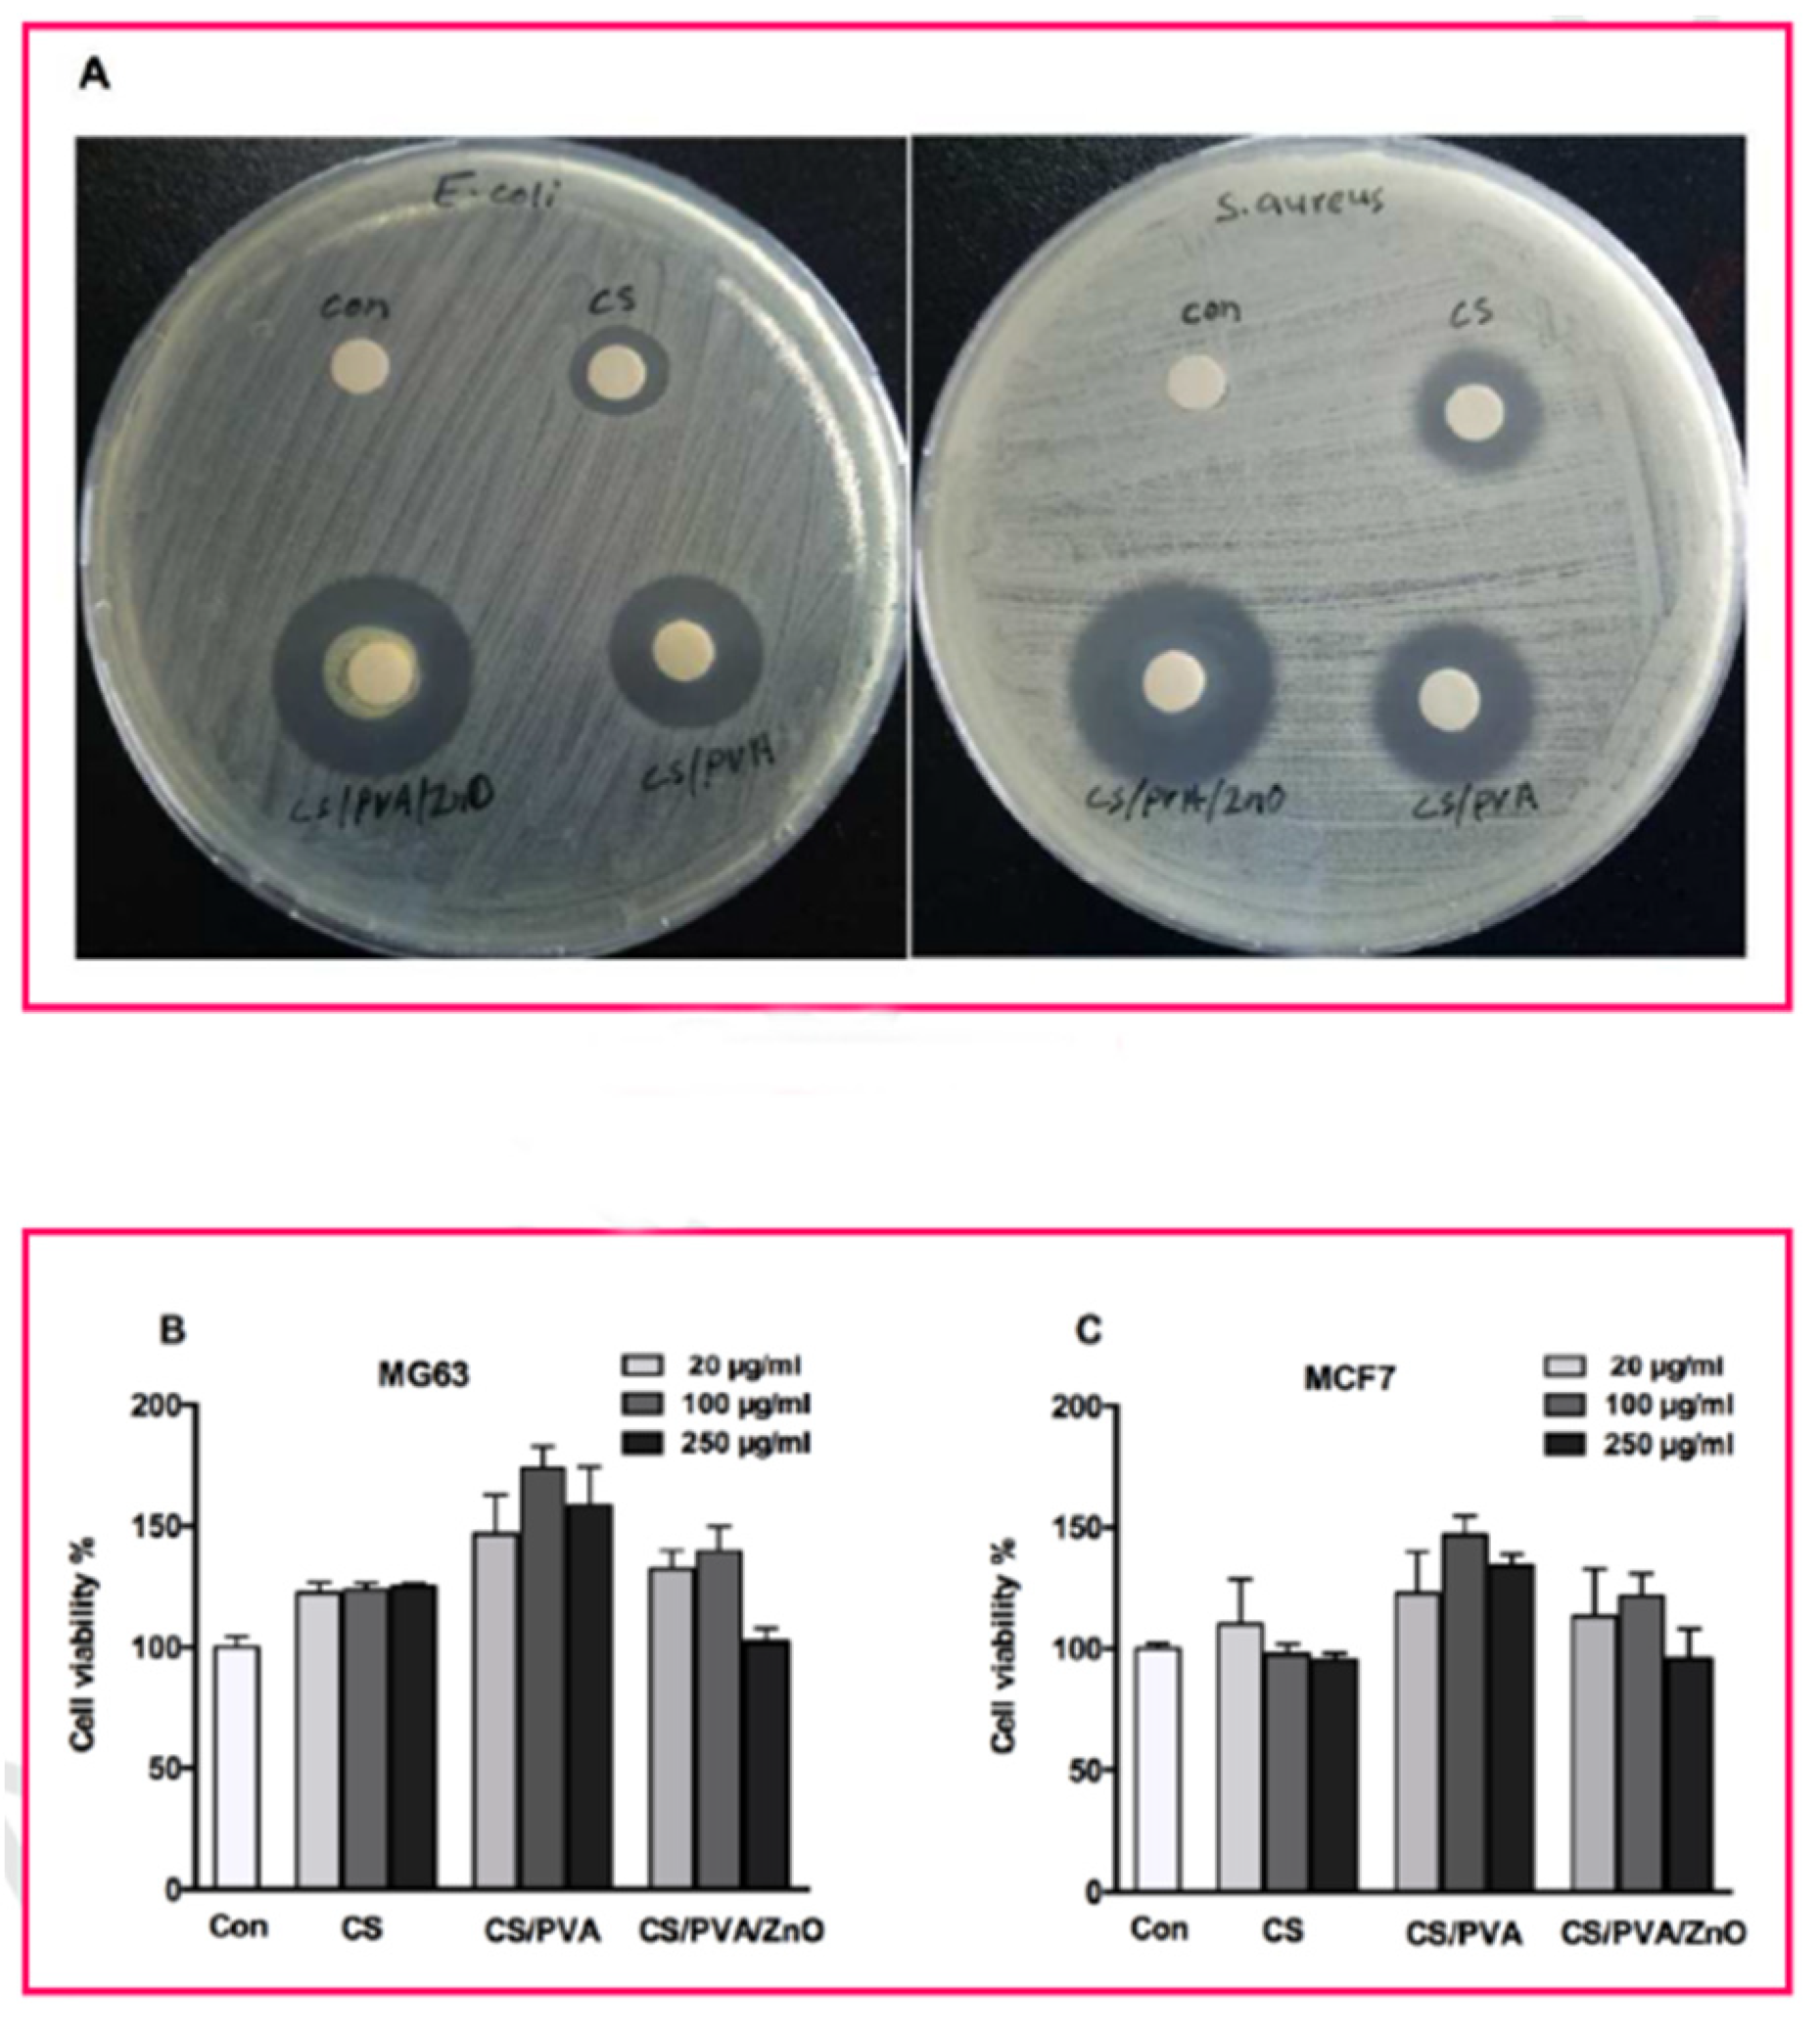
Applsci 12 07910 g023

Recent Progress in ZnO-Based Nanostructures for Photocatalytic Antimicrobial in Water Treatment: A Review
Abstract
:1. Introduction
2. ZnO-Based Nanostructures Preparation
2.1. Sol–Gel Method
2.2. Co-Precipitation Method
2.3. Microwave-Assisted Method
2.4. Hydrothermal Method
3. Types of Nanomaterials for Photocatalytic Antimicrobials in Water Treatment
4. ZnO-Based Nanomaterials for Antimicrobial Application in Water Treatment
4.1. Research Methods for Antimicrobial Activities of ZnO Nanostructures
4.1.1. Disk-Diffusion Method
4.1.2. Well-Diffusion Method
4.1.3. Antimicrobial Measurements in Liquid Culture Media
4.1.4. Colony Unit Measurements
4.1.5. Microtiter Plate Method
4.2. Mechanisms of ZnO-Based Antimicrobial Nanomaterials
4.2.1. Mechanisms of ZnO-Based Photocatalytic
4.2.2. Chemical Effect of ZnO-Based Nanomaterials on Antibacterial
4.2.3. Influence of Physical Effects of ZnO-Based Nanomaterials on Antibacterial Performance
4.3. Effects of Radiation Types on the Antibacterial Activity of ZnO-Based Nanomaterials
4.4. Strategies for Enhancing ZnO-Based Nanomaterials Antibacterial Activity
4.4.1. Alkaline Earth Metal Doping into ZnO
4.4.2. Transition Metals Doping into ZnO
4.4.3. Noble Metals Doping into ZnO
4.4.4. Rare Earth Metal Doping into ZnO
4.4.5. Organic Antimicrobial Agents Doping into ZnO
5. Future Scope and Conclusions
5.1. Future Scope
- (1)
- Exploring strategies for changing the weak toxicity of ZnO-based nanomaterials so that they can be better used in drinking water treatment, clinical medicine, virus killing, and other fields closely related to human beings.
- (2)
- Enhancing the ability of ZnO-based nanomaterials to respond to visible light enables them to have a wider range of applications. Visible light is one of the most abundant light sources, and a better response under visible light can maximize the use of existing energy and reduce investment.
- (3)
- Exploring the use of ZnO-based nanomaterials for photocatalytic removal of resistant bacteria, cancer cells, and other difficult-to-remove microorganisms and pathogen cells to improve the availability of the material.
- (4)
- Exploring stronger ZnO-based nanomaterial structures and carriers to improve recyclability and improve existing problems such as high solubility and difficulty in recycling.
5.2. Conclusions
Author Contributions
Funding
Institutional Review Board Statement
Informed Consent Statement
Data Availability Statement
Conflicts of Interest
References
- Fuzil, N.S.; Othman, N.H.; Alias, N.H.; Marpani, F.; Othman, M.H.D.; Ismail, A.F.; Lau, W.J.; Li, K.; Kusworo, T.D.; Ichinose, I.; et al. A review on photothermal material and its usage in the development of photothermal membrane for sustainable clean water production. Desalination 2021, 517, 115259. [Google Scholar] [CrossRef]
- Tang, W.; Pei, Y.; Zheng, H.; Zhao, Y.; Shu, L.; Zhang, H. Twenty years of China’s water pollution control: Experiences and challenges. Chemosphere 2022, 295, 133875. [Google Scholar] [CrossRef] [PubMed]
- Yan, C.; Qu, Z.; Wang, J.; Cao, L.; Han, Q. Microalgal bioremediation of heavy metal pollution in water: Recent advances, challenges, and prospects. Chemosphere 2022, 286, 131870. [Google Scholar] [CrossRef] [PubMed]
- Aal, N.A.; Al-Hazmi, F.; Al-Ghamdi, A.A.; Alghamdi, A.A.; El-Tantawy, F.; Yakuphanoglu, F. Novel rapid synthesis of zinc oxide nanotubes via hydrothermal technique and antibacterial properties. Spectrochim. Acta Part A Mol. Biomol. Spectrosc. 2015, 135, 871–877. [Google Scholar] [CrossRef]
- Coelho, E.F.; Santos, D.L.; Lima, L.W.F.d.; Castricini, A.; Barros, D.L.; Filgueiras, R.; da Cunha, F.F. Water regimes on soil covered with plastic film mulch and relationships with soil water availability, yield, and water use efficiency of papaya trees. Agric. Water Manag. 2022, 269, 107709. [Google Scholar] [CrossRef]
- Sheikh, M.; Pazirofteh, M.; Dehghani, M.; Asghari, M.; Rezakazemi, M.; Valderrama, C.; Cortina, J.-L. Application of ZnO nanostructures in ceramic and polymeric membranes for water and wastewater technologies: A review. Chem. Eng. J. 2019, 391, 123475. [Google Scholar] [CrossRef]
- Sondermann, M.N.; Proença de Oliveira, R. Using the WEI+ index to evaluate water scarcity at highly regulated river basins with conjunctive uses of surface and groundwater resources. Sci. Total Environ. 2022, 836, 155754. [Google Scholar] [CrossRef]
- Ouassanouan, Y.; Fakir, Y.; Simonneaux, V.; Kharrou, M.H.; Bouimouass, H.; Najar, I.; Benrhanem, M.; Sguir, F.; Chehbouni, A. Multi-decadal analysis of water resources and agricultural change in a Mediterranean semiarid irrigated piedmont under water scarcity and human interaction. Sci. Total Environ. 2022, 834, 155328. [Google Scholar] [CrossRef]
- Kumar, R.; Umar, A.; Kumar, G.; Nalwa, H.S. Antimicrobial properties of ZnO nanomaterials: A review. Ceram. Int. 2017, 43, 3940–3961. [Google Scholar] [CrossRef]
- Witte, W. International dissemination of antibiotic resistant strains of bacterial pathogens. Infect. Genet. Evol. 2004, 4, 187–191. [Google Scholar] [CrossRef]
- Shahin, O.R.; Alshammari, H.H.; Taloba, A.I.; El-Aziz, R.M.A. Machine Learning Approach for Autonomous Detection and Classification of COVID-19 Virus. Comput. Electr. Eng. 2022, 101, 108055. [Google Scholar] [CrossRef] [PubMed]
- Wang, H.; Paulson, K.R.; Pease, S.A.; Watson, S.; Comfort, H.; Zheng, P.; Aravkin, A.Y.; Bisignano, C.; Barber, R.M.; Alam, T.; et al. Estimating excess mortality due to the COVID-19 pandemic: A systematic analysis of COVID-19-related mortality, 2020–2021. Lancet 2022, 399, 1513–1536. [Google Scholar] [CrossRef]
- Flor, L.S.; Friedman, J.; Spencer, C.N.; Cagney, J.; Arrieta, A.; Herbert, M.E.; Stein, C.; Mullany, E.C.; Hon, J.; Patwardhan, V.; et al. Quantifying the effects of the COVID-19 pandemic on gender equality on health, social, and economic indicators: A comprehensive review of data from March, 2020, to September, 2021. Lancet 2022, 399, 2381–2397. [Google Scholar] [CrossRef]
- Pan, D.; Sze, S.; Nazareth, J.; Martin, C.A.; Al-Oraibi, A.; Baggaley, R.F.; Nellums, L.B.; Hollingsworth, T.D.; Tang, J.W.; Pareek, M. Monkeypox in the UK: Arguments for a broader case definition. Lancet 2022, 399, 2345–2346. [Google Scholar] [CrossRef]
- Liu, Y.; Shao, Y.; Wang, L.; Lu, W.; Li, S.; Xu, D.; Fu, Y.V. Inactivation of porcine epidemic diarrhea virus with electron beam irradiation under cold chain conditions. Environ. Technol. Innov. 2022, 27, 102715. [Google Scholar] [CrossRef]
- Yang, S.; Dong, Q.; Li, S.; Cheng, Z.; Kang, X.; Ren, D.; Xu, C.; Zhou, X.; Liang, P.; Sun, L.; et al. Persistence of SARS-CoV-2 RNA in wastewater after the end of the COVID-19 epidemics. J. Hazard. Mater. 2022, 429, 128358. [Google Scholar] [CrossRef] [PubMed]
- Guo, Y.; Lin, S.; Li, X.; Liu, Y. Amino acids assisted hydrothermal synthesis of hierarchically structured ZnO with enhanced photocatalytic activities. Appl. Surf. Sci. 2016, 384, 83–91. [Google Scholar] [CrossRef]
- Chang, Y.-N.; Zhang, M.; Xia, L.; Zhang, J.; Xing, G.J.M. The toxic effects and mechanisms of CuO and ZnO nanoparticles. Creat. Commons Attrib. Licens. 2012, 5, 2850–2871. [Google Scholar] [CrossRef] [Green Version]
- Gupta, K.; Singh, R.P.; Pandey, A.; Pandey, A. Photocatalytic antibacterial performance of TiO2 and Ag-doped TiO2 against S. aureus. P. aeruginosa and E. coli. J. Nanotechnol. 2013, 4, 345–351. [Google Scholar] [CrossRef] [Green Version]
- Allahverdiyev, A.M.; Abamor, E.S.; Bagirova, M.; Rafailovich, M. Antimicrobial effects of TiO2 and Ag2O nanoparticles against drug-resistant bacteria and leishmania parasites. Future Med. 2011, 6, 933–940. [Google Scholar] [CrossRef]
- Jin, T.; He, Y. Antibacterial activities of magnesium oxide (MgO) nanoparticles against foodborne pathogens. J. Nanopart. Res. 2011, 13, 6877–6885. [Google Scholar] [CrossRef]
- Azam, A.; Ahmed, A.S.; Oves, M.; Khan, M.S.; Habib, S.S.; Memic, A. Antimicrobial activity of metal oxide nanoparticles against Gram-positive and Gram-negative bacteria: A comparative study. Int. J. Nanomed. 2012, 7, 6003. [Google Scholar] [CrossRef] [Green Version]
- Luo, Z.; Wu, Q.; Xue, J.; Ding, Y. Selectively enhanced antibacterial effects and ultraviolet activation of antibiotics with ZnO nanorods against Escherichia coli. J. Biomed. Nanotechnol. 2013, 9, 69–76. [Google Scholar] [CrossRef] [PubMed]
- Şahin, B.; Aydin, R.; Soylu, S.; Türkmen, M.; Kara, M.; Akkaya, A.; Çetin, H.; Ayyıldız, E. The effect of thymus syriacus plant extract on the main physical and antibacterial activities of ZnO nanoparticles synthesized by SILAR method. Inorg. Chem. Commun. 2022, 135, 109088. [Google Scholar] [CrossRef]
- Negi, A.; Gangwar, R.; Kumar Vishwakarma, R.; Singh Negi, D. Antibacterial, antioxidant and photodegradation potential of ZnO nanoparticles mediated via roots of Taraxacum officinale radix. Mater. Today Proc. 2022, 57, 2435–2443. [Google Scholar] [CrossRef]
- Etacheri, V.; Di Valentin, C.; Schneider, J.; Bahnemann, D.; Pillai, S.C. Visible-light activation of TiO2 photocatalysts: Advances in theory and experiments. J. Photochem. Photobiol. C Photochem. Rev. 2015, 25, 1–29. [Google Scholar] [CrossRef] [Green Version]
- Qi, K.; Cheng, B.; Yu, J.; Ho, W. Review on the improvement of the photocatalytic and antibacterial activities of ZnO. J. Alloys Compd. 2017, 727, 792–820. [Google Scholar] [CrossRef]
- Zhang, L.; Li, Y.; Liu, X.; Zhao, L.; Ding, Y.; Povey, M.; Cang, D. The properties of ZnO nanofluids and the role of H2O2 in the disinfection activity against Escherichia coli. Water Res. 2013, 47, 4013–4021. [Google Scholar] [CrossRef]
- Ravindranadh, M.R.K.; Mary, T.R. Development of ZnO nanoparticles for clinical applications. J. Chem. Biol. Phys. Sci. 2013, 4, 469. [Google Scholar]
- Zhang, L.; Jiang, Y.; Ding, Y.; Daskalakis, N.; Jeuken, L.; Povey, M.; O’Neill, A.J.; York, D.W. Mechanistic investigation into antibacterial behaviour of suspensions of ZnO nanoparticles against E. coli. J. Nanopart. Res. 2009, 12, 1625–1636. [Google Scholar] [CrossRef]
- Li, M.; Zhu, L.; Lin, D. Toxicity of ZnO Nanoparticles to Escherichia coli: Mechanism and the Influence of Medium Components. Environ. Sci. Technol. 2011, 45, 1977–1983. [Google Scholar] [CrossRef] [PubMed]
- Choubari, M.S.; Mazloom, J.; Ghodsi, F.E. Supercapacitive properties, optical band gap, and photoluminescence of CeO2–ZnO nanocomposites prepared by eco-friendly green and citrate sol-gel methods: A comparative study. Ceram. Int. 2022, 48, 21385–21395. [Google Scholar] [CrossRef]
- Li, Y.; Li, Y.; Fei, Y.; Xie, A.; Li, Y.; Sun, D. Investigation of properties of ZnO and MgxZn1-xO films prepared by sol-gel method. J. Mol. Struct. 2022, 1261, 132959. [Google Scholar] [CrossRef]
- Castro-Lopes, S.; Guerra, Y.; Silva-Sousa, A.; Oliveira, D.M.; Gonçalves, L.A.P.; Franco, A.; Padrón-Hernández, E.; Peña-Garcia, R. Influence of pH on the structural and magnetic properties of Fe-doped ZnO nanoparticles synthesized by sol gel method. Solid State Sci. 2020, 109, 106438. [Google Scholar] [CrossRef]
- Selvaraj, S.; Vangari, G.A.; Mohan, M.K.; Ponnusamy, S.; Muthamizchelvan, C. Facile synthesis of Sm doped ZnO nanoflowers by Co-precipitation method for enhanced photocatalytic degradation of MB dye under sunlight irradiation. Ceram. Int. 2022. [Google Scholar] [CrossRef]
- Shivaraj, B.; Prabhakara, M.C.; Bhojya Naik, H.S.; Indrajith Naik, E.; Viswanath, R.; Shashank, M.; Kumara Swamy, B.E. Optical, bio-sensing, and antibacterial studies on Ni-doped ZnO nanorods, fabricated by chemical co-precipitation method. Inorg. Chem. Commun. 2021, 134, 109049. [Google Scholar] [CrossRef]
- Soltani, S.; Roodbar Shojaei, T.; Khanian, N.; Shean Yaw Choong, T.; Asim, N.; Zhao, Y. Artificial neural network method modeling of microwave-assisted esterification of PFAD over mesoporous TiO2–ZnO catalyst. Renew. Energy 2022, 187, 760–773. [Google Scholar] [CrossRef]
- Saravanan, P.; SenthilKannan, K.; Vimalan, M.; Tamilselvan, S.; Sankar, D. Biofriendly and competent domestic microwave assisted method for the synthesis of ZnO nanoparticles from the extract of Azadirachta indica leaves. Mater. Today Proc. 2020, 33, 3160–3163. [Google Scholar] [CrossRef]
- Ashok, C.H.; Venkateswara Rao, K. ZnO/TiO2 nanocomposite rods synthesized by microwave-assisted method for humidity sensor application. Superlattices Microstruct. 2014, 76, 46–54. [Google Scholar] [CrossRef]
- Li, M.; Xu, Z.P.; Sultanbawa, Y.; Chen, W.; Liu, J.; Qian, G. Potent and durable antibacterial activity of ZnO-dotted nanohybrids hydrothermally derived from ZnAl-layered double hydroxides. Colloids Surf. B Biointerfaces 2019, 181, 585–592. [Google Scholar] [CrossRef]
- Krajian, H.; Abdallah, B.; Kakhia, M.; AlKafri, N. Hydrothermal growth method for the deposition of ZnO films: Structural, chemical and optical studies. Microelectron. Reliab. 2021, 125, 114352. [Google Scholar] [CrossRef]
- Ma, J.; Liu, J.; Bao, Y.; Zhu, Z.; Wang, X.; Zhang, J. Synthesis of large-scale uniform mulberry-like ZnO particles with microwave hydrothermal method and its antibacterial property. Ceram. Int. 2013, 39, 2803–2810. [Google Scholar] [CrossRef]
- Shastri, L.; Qureshi, M.S.; Malik, M.M. Photoluminescence study of ZnO–SiO2 nanostructures grown in silica matrix obtained via sol–gel method. J. Phys. Chem. Solids 2013, 74, 595–598. [Google Scholar] [CrossRef]
- Hassena, H. Photocatalytic degradation of methylene blue by using Al2O3/Fe2O3 nano composite under visible light. Mod. Chem. Appl. 2016, 2016. [Google Scholar] [CrossRef]
- Hasnidawani, J.N.; Azlina, H.N.; Norita, H.; Bonnia, N.N.; Ratim, S.; Ali, E.S. Synthesis of ZnO Nanostructures Using Sol-Gel Method. Procedia Chem. 2016, 19, 211–216. [Google Scholar] [CrossRef] [Green Version]
- Bari, A.R.; Shinde, M.; Deo, V.; Patil, L. Effect of solvents on the particle morphology of nanostructured ZnO. Indian J. Pure Appl. Phys. 2009, 47, 24. [Google Scholar]
- Morkoç, H.; Özgür, Ü. Zinc Oxide: Fundamentals, Materials and Device Technology; John Wiley & Sons: Hoboken, NJ, USA, 2008. [Google Scholar]
- Moezzi, A.; McDonagh, A.M.; Cortie, M.B. Zinc oxide particles: Synthesis, properties and applications. Chem. Eng. J. 2012, 185, 1–22. [Google Scholar] [CrossRef]
- Naik, E.I.; Naik, H.S.B.; Viswanath, R.; Kirthan, B.R.; Prabhakara, M.C. Effect of zirconium doping on the structural, optical, electrochemical and antibacterial properties of ZnO nanoparticles prepared by sol-gel method. Chem. Data Collect. 2020, 29, 100505. [Google Scholar] [CrossRef]
- Chen, Z.; Zhao, X.; Wei, S. Comparative study on sol-gel combined with a hydrothermal synthesis of ZnAl2O4 and ZnO/ZnAl2O4 nanocomposites and its photoluminescence properties and antibacterial activity. Optik 2021, 242, 167151. [Google Scholar] [CrossRef]
- El-Katori, E.E.; Kasim, E.A.; Ali, D.A.J.C.; Physicochemical, S.A.; Aspects, E. Sol–gel synthesis of mesoporous NiO/ZnO heterostructure nanocomposite for photocatalytic and anticorrosive applications in aqueous media. Colloids Surf. A Physicochem. Eng. Asp. 2022, 636, 128153. [Google Scholar] [CrossRef]
- Ahmad, S.; Aadil, M.; Ejaz, S.R.; Akhtar, M.U.; Noor, H.; Haider, S.; Alsafari, I.A.; Yasmin, G.J.C.I. Sol-gel synthesis of nanostructured ZnO/SrZnO2 with boosted antibacterial and photocatalytic activity. Ceram. Int. 2022, 48, 2394–2405. [Google Scholar] [CrossRef]
- Jing, J.; Lin, L.; Yang, K.; Hu, H.; Guo, T.; Li, F.J.O.E. Highly efficient inverted quantum dot light-emitting diodes employing sol-gel derived Li-doped ZnO as electron transport layer. Org. Electron. 2022, 103, 106466. [Google Scholar] [CrossRef]
- Devi, P.G.; Velu, A.S. Synthesis, structural and optical properties of pure ZnO and Co doped ZnO nanoparticles prepared by the co-precipitation method. J. Theor. Appl. Phys. 2016, 10, 233–240. [Google Scholar] [CrossRef] [Green Version]
- Suwanboon, S.; Amornpitoksuk, P.; Sukolrat, A.; Muensit, N.J.C.I. Optical and photocatalytic properties of La-doped ZnO nanoparticles prepared via precipitation and mechanical milling method. Ceram. Int. 2013, 39, 2811–2819. [Google Scholar] [CrossRef]
- Kotresh, M.; Patil, M.; Inamdar, S.J.O. Reaction temperature based synthesis of ZnO nanoparticles using co-precipitation method: Detailed structural and optical characterization. Optik 2021, 243, 167506. [Google Scholar] [CrossRef]
- Anitha, S.; Muthukumaran, S. Structural, optical and antibacterial investigation of La, Cu dual doped ZnO nanoparticles prepared by co-precipitation method. Mater. Sci. Eng. C 2020, 108, 110387. [Google Scholar] [CrossRef]
- Pavithra, M.; Raj, M.J. Influence of ultrasonication time on solar light irradiated photocatalytic dye degradability and antibacterial activity of Pb doped ZnO nanocomposites. Ceram. Int. 2021, 47, 32324–32331. [Google Scholar] [CrossRef]
- Aziz, F.; Abo-Dief, H.M.; Warsi, A.-Z.; Warsi, M.F.; Shahid, M.; Ahmad, T.; Mersal, G.A.; Ibrahim, M.M. Facile synthesis of NiO/ZnO nano-composite by Co-precipitation, characterization and photocatalytic study of colored and colorless organic pollutants by solar irradiation. Phys. B Condens. Matter 2022, 640, 413858. [Google Scholar] [CrossRef]
- Bhogaita, M.; Devaprakasam, D. Hybrid photoanode of TiO2-ZnO synthesized by co-precipitation route for dye-sensitized solar cell using phyllanthus reticulatas pigment sensitizer. Sol. Energy 2021, 214, 517–530. [Google Scholar] [CrossRef]
- Patel, N.; Patel, I.; Bharat, V. Structural, thermal and chemical studies of Mn doped ZnO nanoparticles synthesized by Co-precipitation method. Mater. Proc. 2021, 46, 2277–2280. [Google Scholar] [CrossRef]
- Saleh, S.M. ZnO nanospheres based simple hydrothermal route for photocatalytic degradation of azo dye. Spectrochim. Acta Part A Mol. Biomol. Spectrosc. 2019, 211, 141–147. [Google Scholar] [CrossRef] [PubMed]
- Ahammed, K.R.; Ashaduzzaman, M.; Paul, S.C.; Nath, M.R.; Bhowmik, S.; Saha, O.; Rahaman, M.; Bhowmik, S.; Aka, T. Microwave assisted synthesis of zinc oxide (ZnO) nanoparticles in a noble approach: Utilization for antibacterial and photocatalytic activity. SN Appl. Sci. 2020, 2, 955. [Google Scholar] [CrossRef]
- Sanakousar, F.; Vidyasagar, C.; Jiménez-Pérez, V.; Prakash, K. Recent progress on visible-light-driven metal and non-metal doped ZnO nanostructures for photocatalytic degradation of organic pollutants. Mater. Sci. Semicond. Processing 2022, 140, 106390. [Google Scholar] [CrossRef]
- Arellano-Cortaza, M.; Ramirez-Morales, E.; Pal, U.; Pérez-Hernández, G.; Rojas-Blanco, L. pH dependent morphology and texture evolution of ZnO nanoparticles fabricated by microwave-assisted chemical synthesis and their photocatalytic dye degradation activities. Ceram. Int. 2021, 47, 27469–27478. [Google Scholar] [CrossRef]
- Jin, C.; Lu, Y.; Tong, G.; Che, R.; Xu, H. Excellent microwave absorbing properties of ZnO/ZnFe2O4/Fe core-shell microrods prepared by a rapid microwave-assisted hydrothermal-chemical vapor decomposition method. Appl. Surf. Sci. 2020, 531, 147353. [Google Scholar] [CrossRef]
- Skoda, D.; Urbanek, P.; Sevcik, J.; Munster, L.; Antos, J.; Kuritka, I. Microwave-assisted synthesis of colloidal ZnO nanocrystals and their utilization in improving polymer light emitting diodes efficiency. Mater. Sci. Eng. B 2018, 232–235, 22–32. [Google Scholar] [CrossRef]
- Chong, W.J.; Shen, S.; Li, Y.; Trinchi, A.; Pejak Simunec, D.; Kyratzis, I.; Sola, A.; Wen, C. Biodegradable PLA-ZnO nanocomposite biomaterials with antibacterial properties, tissue engineering viability, and enhanced biocompatibility. Smart Mater. Manuf. 2022, 100004. [Google Scholar] [CrossRef]
- Okeke, I.S.; Agwu, K.K.; Ubachukwu, A.A.; Ezema, F.I. Influence of transition metal doping on physiochemical and antibacterial properties of ZnONanoparticles: A review. Appl. Surf. Sci. Adv. 2022, 8, 100227. [Google Scholar] [CrossRef]
- Kamarulzaman, N.; Kasim, M.F.; Rusdi, R. Band gap narrowing and widening of ZnO nanostructures and doped materials. Nanoscale Res. Lett. 2015, 10, 346. [Google Scholar] [CrossRef] [Green Version]
- Shahmoradi, B.; Ibrahim, I.; Namratha, K.; Sakamoto, N.; Ananda, S.; Somashekar, R.; Byrappa, K. Surface modification of indium doped ZnO hybrid nanoparticles with n-butylamine. Int. J. Chem. Eng. Res. 2010, 2, 107–117. [Google Scholar]
- Sahoo, T.; Kim, M.; Baek, J.H.; Jeon, S.-R.; Kim, J.S.; Yu, Y.-T.; Lee, C.-R.; Lee, I.-H. Synthesis and characterization of porous ZnO nanoparticles by hydrothermal treatment of as pure aqueous precursor. Mater. Res. Bull. 2011, 46, 525–530. [Google Scholar] [CrossRef]
- Yuvarani, A.; Vaideeswaran, R.; Sophia Rani, I.; Reeta Mary, I. Physical characterization and antibacterial activity of zinc oxide nanostructures synthesized via facile hydrothermal method. Mater. Today Proc. 2022. [Google Scholar] [CrossRef]
- Siwińska-Stefańska, K.; Kubiak, A.; Piasecki, A.; Dobrowolska, A.; Czaczyk, K.; Motylenko, M.; Rafaja, D.; Ehrlich, H.; Jesionowski, T. Hydrothermal synthesis of multifunctional TiO2-ZnO oxide systems with desired antibacterial and photocatalytic properties. Appl. Surf. Sci. 2019, 463, 791–801. [Google Scholar] [CrossRef]
- Ashar, A.; Bhatti, I.A.; Siddique, T.; Ibrahim, S.M.; Mirza, S.; Bhutta, Z.A.; Shoaib, M.; Ali, M.; Taj, M.B.; Iqbal, M.; et al. Integrated hydrothermal assisted green synthesis of ZnO nano discs and their water purification efficiency together with antimicrobial activity. J. Mater. Res. Technol. 2021, 15, 6901–6917. [Google Scholar] [CrossRef]
- Chithra, A.; Sekar, R.; Kumar, P.S.; Padmalaya, G.J.C. A review on removal strategies of microorganisms from water environment using nanomaterials and their behavioural characteristics. Chemosphere 2022, 295, 133915. [Google Scholar] [CrossRef] [PubMed]
- Hassouna, M.; ElBably, M.; Mohammed, A.N.; Nasser, M.A.G. Assessment of carbon nanotubes and silver nanoparticles loaded clays as adsorbents for removal of bacterial contaminants from water sources. J. Water Health 2017, 15, 133–144. [Google Scholar] [CrossRef] [PubMed]
- Kokkinos, P.; Mantzavinos, D.; Venieri, D.J.M. Current trends in the application of nanomaterials for the removal of emerging micropollutants and pathogens from water. Molecules 2020, 25, 2016. [Google Scholar] [CrossRef]
- Raghunath, A.; Perumal, E. Metal oxide nanoparticles as antimicrobial agents: A promise for the future. Int. J. Antimicrob. Agents 2017, 49, 137–152. [Google Scholar] [CrossRef]
- Soytaş, S.H.; Oğuz, O.; Menceloğlu, Y.Z. Polymer nanocomposites with decorated metal oxides. In Polymer Composites with Functionalized Nanoparticles; Elsevier: Amsterdam, The Netherlands, 2019; pp. 287–323. [Google Scholar]
- Chen, G.-Q.; Wu, Y.-H.; Wang, Y.-H.; Chen, Z.; Tong, X.; Bai, Y.; Luo, L.-W.; Xu, C.; Hu, H.-Y. Effects of microbial inactivation approaches on quantity and properties of extracellular polymeric substances in the process of wastewater treatment and reclamation: A review. J. Hazard. Mater. 2021, 413, 125283. [Google Scholar] [CrossRef]
- Jayaramudu, T.; Ko, H.-U.; Zhai, L.; Li, Y.; Kim, J. Preparation and characterization of hydrogels from polyvinyl alcohol and cellulose and their electroactive behavior. Soft Mater. 2017, 15, 64–72. [Google Scholar] [CrossRef]
- Dayanidhi, K.; Vadivel, P.; Jothi, S.; Eusuff, N.S. Facile synthesis of Silver@ Eggshell nanocomposite: A heterogeneous catalyst for the removal of heavy metal ions, toxic dyes and microbial contaminants from water. J. Environ. Manag. 2020, 271, 110962. [Google Scholar] [CrossRef] [PubMed]
- Li, J.-F.; Xu, Z.-L.; Yang, H.; Yu, L.-Y.; Liu, M. Effect of TiO2 nanoparticles on the surface morphology and performance of microporous PES membrane. Appl. Surf. Sci. 2009, 255, 4725–4732. [Google Scholar] [CrossRef]
- Suman; Kardam, A.; Gera, M.; Jain, V. A novel reusable nanocomposite for complete removal of dyes, heavy metals and microbial load from water based on nanocellulose and silver nano-embedded pebbles. Environ. Technol. 2015, 36, 706–714. [Google Scholar] [CrossRef]
- Gao, F.; Hou, X.; Wang, A.; Chu, G.; Wu, W.; Chen, J.; Zou, H. Preparation of polypyrrole/TiO2 nanocomposites with enhanced photocatalytic performance. Particuology 2016, 26, 73–78. [Google Scholar] [CrossRef]
- Kalló, D. Applications of natural zeolites in water and wastewater treatment. Rev. Miner. Geochem. 2001, 45, 519–550. [Google Scholar] [CrossRef]
- Inoue, Y.; Hoshino, M.; Takahashi, H.; Noguchi, T.; Murata, T.; Kanzaki, Y.; Hamashima, H.; Sasatsu, M. Bactericidal activity of Ag–zeolite mediated by reactive oxygen species under aerated conditions. J. Inorg. Biochem. 2002, 92, 37–42. [Google Scholar] [CrossRef]
- Lin, S.; Huang, R.; Cheng, Y.; Liu, J.; Lau, B.L.; Wiesner, M.R. Silver nanoparticle-alginate composite beads for point-of-use drinking water disinfection. Water Res. 2013, 47, 3959–3965. [Google Scholar] [CrossRef]
- Song, J.; Kong, H.; Jang, J. Adsorption of heavy metal ions from aqueous solution by polyrhodanine-encapsulated magnetic nanoparticles. J. Colloid Interface Sci. 2011, 359, 505–511. [Google Scholar] [CrossRef]
- Bellanger, X.; Schneider, R.; Dezanet, C.; Arroua, B.; Balan, L.; Billard, P.; Merlin, C. Zn2+ leakage and photo-induced reactive oxidative species do not explain the full toxicity of ZnO core Quantum Dots. J. Hazard. Mater. 2020, 396, 122616. [Google Scholar] [CrossRef]
- Elaaraj, I.; Raouan, S.E.R.; Nakkabi, A.; Es-sounni, B.; Koraichi, I.; El moualij, N.; Fahim, M. Synthesis, characterization and antioxidant, antibacterial activity Zn2+, Cu2+, Ni2+ and Co2+, complexes of ligand [2-(thiophen-2-yl)-1-(thiophen-2-ylmethyl)-1H-benzo[d]imidazole]. J. Indian Chem. Soc. 2022, 99, 100404. [Google Scholar] [CrossRef]
- Ramani, M.; Ponnusamy, S.; Muthamizhchelvan, C.; Cullen, J.; Krishnamurthy, S.; Marsili, E.J.C.; Biointerfaces, S.B. Morphology-directed synthesis of ZnO nanostructures and their antibacterial activity. Colloids Surf. B Biointerfaces 2013, 105, 24–30. [Google Scholar] [CrossRef] [PubMed]
- Jain, A.; Bhargava, R.; Poddar, P. Probing interaction of Gram-positive and Gram-negative bacterial cells with ZnO nanorods. Mater. Sci. Eng. C Mater. Biol. Appl. 2013, 33, 1247–1253. [Google Scholar] [CrossRef] [PubMed]
- Talebian, N.; Amininezhad, S.M.; Doudi, M. Controllable synthesis of ZnO nanoparticles and their morphology-dependent antibacterial and optical properties. J. Photochem. Photobiol. B Biol. 2013, 120, 66–73. [Google Scholar] [CrossRef] [PubMed]
- Jansson, T.; Clare-Salzler, Z.J.; Zaveri, T.D.; Mehta, S.; Dolgova, N.V.; Chu, B.-H.; Ren, F.; Keselowsky, B.G. Antibacterial effects of zinc oxide nanorod surfaces. J. Nanosci. Nanotechnol. 2012, 12, 7132–7138. [Google Scholar] [CrossRef] [PubMed]
- Elumalai, K.; Velmurugan, S.; Ravi, S.; Kathiravan, V.; Ashokkumar, S. RETRACTED: Facile, eco-friendly and template free photosynthesis of cauliflower like ZnO nanoparticles using leaf extract of Tamarindus indica (L.) and its biological evolution of antibacterial and antifungal activities. Spectrochim. Part A Mol. Biomol. Spectrosc. 2015, 136, 1052–1057. [Google Scholar] [CrossRef]
- Wahab, R.; Kim, Y.-S.; Mishra, A.; Yun, S.-I.; Shin, H.-S. Formation of ZnO micro-flowers prepared via solution process and their antibacterial activity. Nanoscale Res. Lett. 2010, 5, 1675–1681. [Google Scholar] [CrossRef] [Green Version]
- Kumar, K.M.; Mandal, B.K.; Naidu, E.A.; Sinha, M.; Kumar, K.S.; Reddy, P.S. Synthesis and characterisation of flower shaped zinc oxide nanostructures and its antimicrobial activity. Spectrochim. Acta Part A-Mol. Biomol. Spectrosc. 2013, 104, 171–174. [Google Scholar] [CrossRef]
- Khan, M.F.; Hameedullah, M.; Ansari, A.H.; Ahmad, E.; Lohani, M.; Khan, R.H.; Alam, M.M.; Khan, W.; Husain, F.M.; Ahmad, I. Flower-shaped ZnO nanoparticles synthesized by a novel approach at near-room temperatures with antibacterial and antifungal properties. Int. J. Nanomed. 2014, 9, 853. [Google Scholar] [CrossRef]
- Umar, A.; Chauhan, M.; Chauhan, S.; Kumar, R.; Sharma, P.; Tomar, K.J.; Wahab, R.; Al-Hajry, A.; Singh, D. Applications of ZnO nanoflowers as antimicrobial agents for Escherichia coli and enzyme-free glucose sensor. J. Biomed. Nanotechnol. 2013, 9, 1794–1802. [Google Scholar] [CrossRef]
- Shinde, V.V.; Dalavi, D.S.; Mali, S.S.; Hong, C.K.; Kim, J.H.; Patil, P.S. Surfactant free microwave assisted synthesis of ZnO microspheres: Study of their antibacterial activity. Appl. Surf. Sci. 2014, 307, 495–502. [Google Scholar] [CrossRef]
- Liu, Y.; He, L.; Mustapha, A.; Li, H.; Hu, Z.; Lin, M. Antibacterial activities of zinc oxide nanoparticles against Escherichia coli O157:H7. J. Appl. Microbiol. 2009, 107, 1193–1201. [Google Scholar] [CrossRef] [PubMed]
- Abboud-Abi Saab, M.; Hassoun, A.E.R. Effects of organic pollution on environmental conditions and the phytoplankton community in the central Lebanese coastal waters with special attention to toxic algae. Reg. Stud. Mar. Sci. 2017, 10, 38–51. [Google Scholar] [CrossRef]
- Yousef, J.M.; Danial, E.N. In Vitro Antibacterial Activity and Minimum Inhibitory Concentration of Zinc Oxide and Nano-particle Zinc oxide Against Pathogenic Strains. Int. J. Health Sci. 2012, 2, 38–42. [Google Scholar] [CrossRef] [Green Version]
- Wahab, R.; Khan, F.; Lutfullah; Singh, R.; Khan, A. Enhance antimicrobial activity of ZnO nanomaterial׳s (QDs and NPs) and their analytical applications. Phys. E: Low-Dimens. Syst. Nanostruct. 2014, 62, 111–117. [Google Scholar] [CrossRef]
- Carvalho, P.; Sampaio, P.; Azevedo, S.; Vaz, C.; Espinos, J.P.; Teixeira, V.; Carneiro, J. Influence of thickness and coatings morphology in the antimicrobial performance of zinc oxide coatings. Appl. Surf. Sci. 2014, 307, 548–557. [Google Scholar] [CrossRef] [Green Version]
- Palanikumar, L.; Ramasamy, S.N.; Balachandran, C. Size-dependent antimicrobial response of zinc oxide nanoparticles. IET Nanobiotechnol. 2014, 8, 111–117. [Google Scholar] [CrossRef]
- Dutta, R.K.; Nenavathu, B.P.; Gangishetty, M.K. Correlation between defects in capped ZnO nanoparticles and their antibacterial activity. J. Photochem. Photobiol. B Biol. 2013, 126, 105–111. [Google Scholar] [CrossRef]
- Sharma, S.; Bhattacharya, A. Drinking water contamination and treatment techniques. Appl. Water Sci. 2017, 7, 1043–1067. [Google Scholar] [CrossRef] [Green Version]
- Dinesha, B.; Sharanagouda, H.; Udaykumar, N.; Ramachandr, C.; Dandekar, A.B. Removal of Pollutants from Water/Waste Water Using Nano-Adsorbents: A Potential Pollution Mitigation. Int. J. Curr. Microbiol. Appl. Sci. 2017, 6, 4868–4872. [Google Scholar] [CrossRef]
- Abu Hasan, H.; Muhammad, M.H.; Ismail, N. A review of biological drinking water treatment technologies for contaminants removal from polluted water resources. J. Water Process Eng. 2019, 33, 101035. [Google Scholar] [CrossRef]
- Mukherjee, M.; De, S. Reduction of microbial contamination from drinking water using an iron oxide nanoparticle-impregnated ultrafiltration mixed matrix membrane: Preparation, characterization and antimicrobial properties. Environ. Sci. Water Res. Technol. 2015, 1, 204–217. [Google Scholar] [CrossRef]
- Valbonesi, P.; Profita, M.; Vasumini, I.; Fabbri, E. Contaminants of emerging concern in drinking water: Quality assessment by combining chemical and biological analysis. Sci. Total Environ. 2020, 758, 143624. [Google Scholar] [CrossRef] [PubMed]
- Hartmann, J.; van Driezum, I.; Ohana, D.; Lynch, G.; Berendsen, B.; Wuijts, S.; van der Hoek, J.P.; Husman, A.M.D.R. The effective design of sampling campaigns for emerging chemical and microbial contaminants in drinking water and its resources based on literature mining. Sci. Total Environ. 2020, 742, 140546. [Google Scholar] [CrossRef] [PubMed]
- Sanaeepur, H.; Ebadi Amooghin, A.; Shirazi, M.M.A.; Pishnamazi, M.; Shirazian, S. Water desalination and ion removal using mixed matrix electrospun nanofibrous membranes: A critical review. Desalination 2022, 521, 115350. [Google Scholar] [CrossRef]
- Ali, A.; Gul, A.; Mannan, A.; Zia, M. Efficient metal adsorption and microbial reduction from Rawal Lake wastewater using metal nanoparticle coated cotton. Sci. Total Environ. 2018, 639, 26–39. [Google Scholar] [CrossRef]
- Ahmed, M.B.; Zhou, J.L.; Ngo, H.H.; Guo, W. Adsorptive removal of antibiotics from water and wastewater: Progress and challenges. Sci. Total Environ. 2015, 532, 112–126. [Google Scholar] [CrossRef]
- Marcińczyk, M.; Ok, Y.S.; Oleszczuk, P. From waste to fertilizer: Nutrient recovery from wastewater by pristine and engineered biochars. Chemosphere 2022, 306, 135310. [Google Scholar] [CrossRef]
- Zahmatkesh, S.; Far, S.S.; Sillanpää, M. RSM-D-optimal modeling approach for COD removal from low strength wastewater by microalgae, sludge, and activated carbon- case study Mashhad. J. Hazard. Mater. Adv. 2022, 7, 100110. [Google Scholar] [CrossRef]
- Azam, K.; Shezad, N.; Shafiq, I.; Akhter, P.; Akhtar, F.; Jamil, F.; Shafique, S.; Park, Y.-K.; Hussain, M. A review on activated carbon modifications for the treatment of wastewater containing anionic dyes. Chemosphere 2022, 135566. [Google Scholar] [CrossRef]
- Srivastava, N.; Chattopadhyay, J. Effective utilization of biofiltration techniques for removal of pathogenic microorganisms from wastewater treatment plants. In An Innovative Role of Biofiltration in Wastewater Treatment Plants (WWTPs); Shah, M., Rodriguez-Couto, S., Biswas, J., Eds.; Elsevier: Amsterdam, The Netherlands, 2022; pp. 207–216. [Google Scholar] [CrossRef]
- Rani, M.; Paul, B.; Bhattacharjee, A.; Das, K.; Singh, P.; Basu, S.; Pandey, S.; Tripathi, D.; Kumar, A. Detection and removal of pathogenic bacteria from wastewater using various nanoparticles. In Development in Wastewater Treatment Research and Processes; Shah, M., Rodriguez-Couto, S., Biswas, J., Eds.; Elsevier: Amsterdam, The Netherlands, 2022; pp. 311–322. [Google Scholar] [CrossRef]
- Rikta, S.Y. Application of nanoparticles for disinfection and microbial control of water and wastewater. Nanotechnol. Water Wastewater Treat. Theory Appl. 2019, 159–176. [Google Scholar] [CrossRef]
- Amin, M.; Alazba, A.; Manzoor, U. A review of removal of pollutants from water/wastewater using different types of nanomaterials. Adv. Mater. Sci. Eng. 2014, 2014, 825910. [Google Scholar] [CrossRef] [Green Version]
- Priyadarshni, N.; Nath, P.; Chanda, N. Sustainable removal of arsenate, arsenite and bacterial contamination from water using biochar stabilized iron and copper oxide nanoparticles and associated mechanism of the remediation process. J. Water Process Eng. 2020, 37, 101495. [Google Scholar] [CrossRef]
- Gebre, S.H.; Sendeku, M.G. New frontiers in the biosynthesis of metal oxide nanoparticles and their environmental applications: An overview. Appl. Sci. 2019, 1, 928. [Google Scholar] [CrossRef] [Green Version]
- Borhani, S.; Asadi, A.; Dabbagh, H.A. Preparation and characterization of PAN nanofibers containing boehmite nanoparticles for the removal of microbial contaminants and cadmium ions from water. J. Water Health 2020, 18, 106–117. [Google Scholar] [CrossRef] [PubMed]
- Fahimirad, S.; Fahimirad, Z.; Sillanpää, M. Efficient removal of water bacteria and viruses using electrospun nanofibers. Sci. Total Environ. 2021, 751, 141673. [Google Scholar] [CrossRef]
- Rivera-Utrilla, J.; Bautista-Toledo, I.; Ferro-García, M.A.; Moreno-Castilla, C. Activated carbon surface modifications by adsorption of bacteria and their effect on aqueous lead adsorption. J. Chem. Technol. Biotechnol. 2001, 76, 1209–1215. [Google Scholar] [CrossRef] [Green Version]
- Hassan, M.; Abou-Zeid, R.; Hassan, E.; Berglund, L.; Aitomäki, Y.; Oksman, K.J.P. Membranes based on cellulose nanofibers and activated carbon for removal of Escherichia coli bacteria from water. Polymers 2017, 9, 335. [Google Scholar] [CrossRef] [Green Version]
- Hussain, S.; de Las Heras, N.; Asghar, H.; Brown, N.; Roberts, E. Disinfection of water by adsorption combined with electrochemical treatment. Water Res. 2014, 54, 170–178. [Google Scholar] [CrossRef]
- Dubreuil, L.; Jehl, F.; Cattoen, C.; Bonnet, R.; Bru, J.P.; Caron, F.; Cattoir, V.; Courvalin, P.; Jarlier, V.; Lina, G.; et al. Improvement of a disk diffusion method for antibiotic susceptibility testing of anaerobic bacteria. French recommendations revisited for 2020. Anaerobe 2020, 64, 102213. [Google Scholar] [CrossRef]
- Jan, T.; Azmat, S.; Rahman, A.U.; Ilyas, S.; Mehmood, A. Experimental and DFT study of Al doped ZnO nanoparticles with enhanced antibacterial activity. Ceram. Int. 2022, 48, 20838–20847. [Google Scholar] [CrossRef]
- Chennimalai, M.; Vijayalakshmi, V.; Senthil, T.; Sivakumar, N. One-step green synthesis of ZnO nanoparticles using Opuntia humifusa fruit extract and their antibacterial activities. Mater. Today Proc. 2021, 47, 1842–1846. [Google Scholar] [CrossRef]
- Pauzi, N.; Zain, N.M.; Kutty, R.V.; Ramli, H. Antibacterial and antibiofilm properties of ZnO nanoparticles synthesis using gum arabic as a potential new generation antibacterial agent. Mater. Today Proc. 2020, 41, 1–8. [Google Scholar] [CrossRef]
- Ramesh, M.; Anbuvannan, M.; Viruthagiri, G. Green synthesis of ZnO nanoparticles using Solanum nigrum leaf extract and their antibacterial activity. Spectrochim. Acta Part A Mol. Biomol. Spectrosc. 2015, 136, 864–870. [Google Scholar] [CrossRef] [PubMed]
- Huang, Z.; Zheng, X.; Yan, D.; Yin, G.; Liao, X.; Kang, Y.; Yao, Y.; Huang, D.; Hao, B. Toxicological Effect of ZnO Nanoparticles Based on Bacteria. Langmuir 2008, 24, 4140–4144. [Google Scholar] [CrossRef]
- Suresh, D.; Udayabhanu; Nethravathi, P.; Lingaraju, K.; Rajanaika, H.; Sharma, S.; Nagabhushana, H. EGCG assisted green synthesis of ZnO nanopowders: Photodegradative, antimicrobial and antioxidant activities. Spectrochim. Acta Part A Mol. Biomol. Spectrosc. 2015, 136, 1467–1474. [Google Scholar] [CrossRef]
- Roy, S.; Barua, N.; Buragohain, A.K.; Ahmed, G.A. Study of ZnO nanoparticles: Antibacterial property and light depolarization property using light scattering tool. J. Quant. Spectrosc. Radiat. Transf. 2013, 118, 8–13. [Google Scholar] [CrossRef]
- Ambika, S.; Sundrarajan, M. Antibacterial behaviour of Vitex negundo extract assisted ZnO nanoparticles against pathogenic bacteria. J. Photochem. Photobiol. B Biol. 2015, 146, 52–57. [Google Scholar] [CrossRef]
- Gudkov, S.V.; Burmistrov, D.E.; Serov, D.A.; Rebezov, M.B.; Semenova, A.A.; Lisitsyn, A.B. A Mini Review of Antibacterial Properties of ZnO Nanoparticles. Front. Phys. 2021, 9, 641481. [Google Scholar] [CrossRef]
- Kairyte, K.; Kadys, A.; Luksiene, Z. Antibacterial and antifungal activity of photoactivated ZnO nanoparticles in suspension. J. Photochem. Photobiol. B Biol. 2013, 128, 78–84. [Google Scholar] [CrossRef]
- Raghupathi, K.R.; Koodali, R.T.; Manna, A.C. Size-Dependent Bacterial Growth Inhibition and Mechanism of Antibacterial Activity of Zinc Oxide Nanoparticles. Langmuir 2011, 27, 4020–4028. [Google Scholar] [CrossRef]
- Jaber, G.S.; Khashan, K.S.; Abbas, M.J. Study the antibacterial activity of zinc oxide nanoparticles synthesis by laser ablation in liquid. Mater. Today Proc. 2021, 42, 2668–2673. [Google Scholar] [CrossRef]
- Rao, S.M.; Kotteeswaran, S.; Visagamani, A.M. Green synthesis of zinc oxide nanoparticles from camellia sinensis: Organic dye degradation and antibacterial activity. Inorg. Chem. Commun. 2021, 134, 108956. [Google Scholar] [CrossRef]
- Nallal, V.U.; Prabha, K.; Muthupandi, S.; Razia, M. Synergistic antibacterial potential of plant-based zinc oxide nanoparticles in combination with antibiotics against Pseudomonas aeruginosa. Mater. Proc. 2022, 49, 2632–2635. [Google Scholar] [CrossRef]
- Ng, Y.; Leung, Y.; Liu, F.; Ng, A.; Gao, M.; Chan, C.; Djurišić, A.; Leung, F.; Chan, W. Antibacterial activity of ZnO nanoparticles under ambient illumination—The effect of nanoparticle properties. Thin Solid Films 2013, 542, 368–372. [Google Scholar] [CrossRef]
- Weldegebrieal, G.K. Synthesis method, antibacterial and photocatalytic activity of ZnO nanoparticles for azo dyes in wastewater treatment: A review. Inorg. Chem. Commun. 2020, 120, 108140. [Google Scholar] [CrossRef]
- Dyshlyuk, L.; Babich, O.; Ivanova, S.; Vasilchenco, N.; Prosekov, A.; Sukhikh, S. Suspensions of metal nanoparticles as a basis for protection of internal surfaces of building structures from biodegradation. Case Stud. Constr. Mater. 2019, 12, e00319. [Google Scholar] [CrossRef]
- Zudyte, B.; Luksiene, Z. Visible light-activated ZnO nanoparticles for microbial control of wheat crop. J. Photochem. Photobiol. B Biol. 2021, 219, 112206. [Google Scholar] [CrossRef]
- Stanković, A.; Dimitrijević, S.; Uskoković, D. Influence of size scale and morphology on antibacterial properties of ZnO powders hydrothemally synthesized using different surface stabilizing agents. Colloids Surfaces B Biointerfaces 2013, 102, 21–28. [Google Scholar] [CrossRef]
- Premanathan, M.; Karthikeyan, K.; Jeyasubramanian, K.; Manivannan, G. Selective toxicity of ZnO nanoparticles toward Gram-positive bacteria and cancer cells by apoptosis through lipid peroxidation. Nanomed.-Nanotechnol. Biol. Med. 2011, 7, 184–192. [Google Scholar] [CrossRef]
- Papavlassopoulos, H.; Mishra, Y.K.; Kaps, S.; Paulowicz, I.; Abdelaziz, R.; Elbahri, M.; Maser, E.; Adelung, R.; Röhl, C. Toxicity of Functional Nano-Micro Zinc Oxide Tetrapods: Impact of Cell Culture Conditions, Cellular Age and Material Properties. PLoS ONE 2014, 9, e84983. [Google Scholar] [CrossRef] [Green Version]
- Gupta, S.M.; Tripathi, M. A review of TiO2 nanoparticles. Chin. Sci. Bull. 2011, 56, 1639–1657. [Google Scholar] [CrossRef] [Green Version]
- Yu, M.; Ma, Y.; Liu, J.; Li, X.; Li, S.; Liu, S. Sub-coherent growth of ZnO nanorod arrays on three-dimensional graphene framework as one-bulk high-performance photocatalyst. Appl. Surf. Sci. 2016, 390, 266–272. [Google Scholar] [CrossRef]
- Bera, S.; Pal, M.; Naskar, A.; Jana, S. J Hierarchically structured ZnO-graphene hollow microspheres towards effective reusable adsorbent for organic pollutant via photodegradation process. J. Alloys Compd. 2016, 669, 177–186. [Google Scholar] [CrossRef]
- Lakshmi Prasanna, V.; Vijayaraghavan, R. Insight into the mechanism of antibacterial activity of ZnO: Surface defects mediated reactive oxygen species even in the dark. Langmuir 2015, 31, 9155–9162. [Google Scholar] [CrossRef] [PubMed]
- Pasquet, J.; Chevalier, Y.; Pelletier, J.; Couval, E.; Bouvier, D.; Bolzinger, M.-A.J.C.; Physicochemical, S.A.; Aspects, E. The contribution of zinc ions to the antimicrobial activity of zinc oxide. Colloids Surf. A Physicochem. Eng. Asp. 2014, 457, 263–274. [Google Scholar] [CrossRef]
- Song, W.; Zhang, J.; Guo, J.; Zhang, J.; Ding, F.; Li, L.; Sun, Z. Role of the dissolved zinc ion and reactive oxygen species in cytotoxicity of ZnO nanoparticles. Toxicol. Lett. 2010, 199, 389–397. [Google Scholar] [CrossRef] [PubMed]
- Zhang, L.; Jiang, Y.; Ding, Y.; Povey, M.; York, D. Investigation into the antibacterial behaviour of suspensions of ZnO nanoparticles (ZnO nanofluids). J. Nanopart. Res. 2007, 9, 479–489. [Google Scholar] [CrossRef]
- Sawai, J.; Shoji, S.; Igarashi, H.; Hashimoto, A.; Kokugan, T.; Shimizu, M.; Kojima, H. Hydrogen peroxide as an antibacterial factor in zinc oxide powder slurry. J. Ferment. Bioeng. 1998, 86, 521–522. [Google Scholar] [CrossRef]
- Stoimenov, P.K.; Klinger, R.L.; Marchin, G.L.; Klabunde, K. Metal oxide nanoparticles as bactericidal agents. Langmuir 2002, 18, 6679–6686. [Google Scholar] [CrossRef]
- Choi, O.; Deng, K.K.; Kim, N.-J.; Ross Jr, L.; Surampalli, R.Y.; Hu, Z. The inhibitory effects of silver nanoparticles, silver ions, and silver chloride colloids on microbial growth. Water Res. 2008, 42, 3066–3074. [Google Scholar] [CrossRef]
- Padmavathy, N.; Vijayaraghavan, R. Enhanced bioactivity of ZnO nanoparticles—An antimicrobial study. Sci. Technol. Adv. Mater. 2008, 9, 035004. [Google Scholar] [CrossRef] [PubMed]
- Sharma, V.K.; Yngard, R.A.; Lin, Y. Silver nanoparticles: Green synthesis and their antimicrobial activities. Adv. Colloid Interface Sci. 2009, 145, 83–96. [Google Scholar] [CrossRef] [PubMed]
- Lok, C.-N.; Ho, C.-M.; Chen, R.; He, Q.-Y.; Yu, W.-Y.; Sun, H.; Tam, P.K.-H.; Chiu, J.-F.; Che, C.-M. Proteomic analysis of the mode of antibacterial action of silver nanoparticles. J. Proteome Res. 2006, 5, 916–924. [Google Scholar] [CrossRef] [PubMed]
- Rai, M.; Yadav, A.; Gade, A. Silver nanoparticles as a new generation of antimicrobials. Biotechnol. Adv. 2009, 27, 76–83. [Google Scholar] [CrossRef]
- Alabresm, A.; Decho, A.W.; Lead, J. A novel method to estimate cellular internalization of nanoparticles into gram-negative bacteria: Non-lytic removal of outer membrane and cell wall. Nanoimpact 2021, 21, 100283. [Google Scholar] [CrossRef]
- Liu, L.; Xu, K.; Zhang, B.; Ye, Y.; Zhang, Q.; Jiang, W. Cellular internalization and release of polystyrene microplastics and nanoplastics. Sci. Total Environ. 2021, 779, 146523. [Google Scholar] [CrossRef]
- Zhao, Z.; Yang, S.; Yang, P.; Lin, J.; Fan, J.; Zhang, B. Study of oxygen-deficient W18O49-based drug delivery system readily absorbed through cellular internalization pathways in tumor-targeted chemo-/photothermal therapy. Biomater. Adv. 2022, 136, 212772. [Google Scholar] [CrossRef]
- Tam, K.H.; Djurišić, A.B.; Chan, C.M.N.; Xi, Y.Y.; Tse, C.W.; Leung, Y.H.; Chan, W.K.; Leung, F.C.C.; Au, D.W.T. Antibacterial activity of ZnO nanorods prepared by a hydrothermal method. Thin Solid Film. 2008, 516, 6167–6174. [Google Scholar] [CrossRef]
- Sun, J.e.; Cai, S.; Li, Q.; Li, Z.; Xu, G. UV-irradiation induced biological activity and antibacterial activity of ZnO coated magnesium alloy. Mater. Sci. Eng. C 2020, 114, 110997. [Google Scholar] [CrossRef]
- Joe, A.; Park, S.-H.; Kim, D.-J.; Lee, Y.-J.; Jhee, K.-H.; Sohn, Y.; Jang, E.-S. Antimicrobial activity of ZnO nanoplates and its Ag nanocomposites: Insight into an ROS-mediated antibacterial mechanism under UV light. J. Solid State Chem. 2018, 267, 124–133. [Google Scholar] [CrossRef]
- Sroila, W.; Kantarak, E.; Kumpika, T.; Bovonsombut, S.; Thongmanee, P.; Singjai, P.; Thongsuwan, W. Antibacterial activity absence UV irradiation of Ag, TiO2 and ZnO NPs prepared by sparking method. Mater. Today Proc. 2019, 17, 1569–1574. [Google Scholar] [CrossRef]
- Ma, W.; Li, L.; Liu, Y.; Sun, Y.; Kim, I.S.; Ren, X. Tailored assembly of vinylbenzyl N-halamine with end-activated ZnO to form hybrid nanoparticles for quick antibacterial response and enhanced UV stability. J. Alloy. Compd. 2019, 797, 692–701. [Google Scholar] [CrossRef]
- Nenavathu, B.P.; Kandula, S.; Verma, S. Visible-light-driven photocatalytic degradation of safranin-T dye using functionalized graphene oxide nanosheet (FGS)/ZnO nanocomposites. RSC Adv. 2018, 8, 19659–19667. [Google Scholar] [CrossRef] [PubMed] [Green Version]
- Sudrajat, H.; Babel, S. A novel visible light active N-doped ZnO for photocatalytic degradation of dyes. J. Water Process Eng. 2017, 16, 309–318. [Google Scholar] [CrossRef]
- Jin, Y.; Long, J.; Ma, X.; Zhou, T.; Zhang, Z.; Lin, H.; Long, J.; Wang, X. Synthesis of caged iodine-modified ZnO nanomaterials and study on their visible light photocatalytic antibacterial properties. Appl. Catal. B Environ. 2019, 256, 117873. [Google Scholar] [CrossRef]
- Liang, Y.; Li, W.; Wang, X.; Zhou, R.; Ding, H. TiO2–ZnO/Au ternary heterojunction nanocomposite: Excellent antibacterial property and visible-light photocatalytic hydrogen production efficiency. Ceram. Int. 2022, 48, 2826–2832. [Google Scholar] [CrossRef]
- Chen, L.; Chuang, Y.; Chen, C.-W.; Dong, C.-D. Facile synthesis of MoS2/ZnO quantum dots for enhanced visible-light photocatalytic performance and antibacterial applications. Nano-Struct. Nano-Objects 2022, 30, 100873. [Google Scholar] [CrossRef]
- Yang, Y.; Wu, Z.; Yang, R.; Li, Y.; Liu, X.; Zhang, L.; Yu, B. Insights into the mechanism of enhanced photocatalytic dye degradation and antibacterial activity over ternary ZnO/ZnSe/MoSe2 photocatalysts under visible light irradiation. Appl. Surf. Sci. 2021, 539, 148220. [Google Scholar] [CrossRef]
- Xin, Z.; Wang, S.; He, Q.; Han, X.; Fu, Z.; Xu, X.; Zhao, X. Preparation of a novel photocatalytic catalyst PW9@ZnO/Ag and the photocatalytic degradation of butyl xanthate under visible light. Environ. Res. 2022, 214, 113776. [Google Scholar] [CrossRef]
- Ye, W.; Jiang, Y.; Liu, Q.; Xu, D.; Zhang, E.; Cheng, X.; Wan, Z.; Liu, C. The preparation of visible light-driven ZnO/Ag2MoO4/Ag nanocomposites with effective photocatalytic and antibacterial activity. J. Alloys Compd. 2022, 891, 161898. [Google Scholar] [CrossRef]
- Samuel, J.; Suresh, S.; Shabna, S.; Sherlin Vinita, V.; Joslin Ananth, N.; Shajin Shinu, P.M.; Mariappan, A.; simon, T.; Samson, Y.; Biju, C.S. Characterization and antibacterial activity of Ti doped ZnO nanorods prepared by hydrazine assisted wet chemical route. Phys. E Low-Dimens. Syst. Nanostruct. 2022, 143, 115374. [Google Scholar] [CrossRef]
- Shkir, M.; Al-Shehri, B.M.; Pachamuthu, M.; Khan, A.; Chandekar, K.V.; AlFaify, S.; Hamdy, M.S. A remarkable improvement in photocatalytic activity of ZnO nanoparticles through Sr doping synthesized by one pot flash combustion technique for water treatments. Colloids Surf. A-Physicochem. Eng. Asp. 2020, 587, 124340. [Google Scholar] [CrossRef]
- Kumaran, N.N.; Muraleedharan, K. Photocatalytic activity of ZnO and Sr2+ doped ZnO nanoparticles. J. Water Process Eng. 2017, 17, 264–270. [Google Scholar] [CrossRef]
- Okeke, I.; Agwu, K.; Ubachukwu, A.; Madiba, I.; Maaza, M.; Whyte, G.; Ezema, F. Impact of particle size and surface defects on antibacterial and photocatalytic activities of undoped and Mg-doped ZnO nanoparticles, biosynthesized using one-step simple process. Vacuum 2021, 187, 110110. [Google Scholar] [CrossRef]
- Grace, A.N.; Pandian, K. Antibacterial efficacy of aminoglycosidic antibiotics protected gold nanoparticles—A brief study. Colloids Surf. A Physicochem. Eng. Asp. 2007, 297, 63–70. [Google Scholar] [CrossRef]
- Ma, Q.; Yang, X.; Lv, X.; Jia, H.; Wang, Y. Cu doped ZnO hierarchical nanostructures: Morphological evolution and photocatalytic property. J. Mater. Sci.-Mater. Electron. 2019, 30, 2309–2315. [Google Scholar] [CrossRef]
- Kuriakose, S.; Satpati, B.; Mohapatra, S. Highly efficient photocatalytic degradation of organic dyes by Cu doped ZnO nanostructures. Phys. Chem. Chem. Phys. 2015, 17, 25172–25181. [Google Scholar] [CrossRef]
- Chandramouli, K.; Suryanarayana, B.; Babu, T.A.; Raghavendra, V.; Parajuli, D.; Murali, N.; Malapati, V.; Mammo, T.W.; Shanmukhi, P.; Gudla, U.R.J.S.; et al. Synthesis, structural and antibacterial activity of pure, Fe doped, and glucose capped ZnO nanoparticles. Surf. Interfaces 2021, 26, 101327. [Google Scholar] [CrossRef]
- Moussa, D.; Bakeer, D.E.-S.; Awad, R.; Abdel-Gaber, A. Physical properties of ZnO nanoparticles doped with Mn and Fe. In Journal of Physics: Conference Series; IOP Publishing: Bristol, UK, 2017; p. 012021. [Google Scholar]
- Ahmad, M.; Ahmed, E.; Zafar, F.; Khalid, N.; Niaz, N.; Hafeez, A.; Ikram, M.; Khan, M.A.; Zhanglian, H. Enhanced photocatalytic activity of Ce-doped ZnO nanopowders synthesized by combustion method. J. Rare Earths 2015, 33, 255–262. [Google Scholar] [CrossRef]
- Mohammadzadeh Kakhki, R.; Tayebee, R.; Ahsani, F. New and highly efficient Ag doped ZnO visible nano photocatalyst for removing of methylene blue. J. Mater. Sci.-Mater. Electron. 2017, 28, 5941–5952. [Google Scholar] [CrossRef]
- Raza, W.; Faisal, S.M.; Owais, M.; Bahnemann, D.; Muneer, M. Facile fabrication of highly efficient modified ZnO photocatalyst with enhanced photocatalytic, antibacterial and anticancer activity. RSC Adv. 2016, 6, 78335–78350. [Google Scholar] [CrossRef] [Green Version]
- Weber, A.S.; Grady, A.M.; Koodali, R.T. Lanthanide modified semiconductor photocatalysts. Catal. Sci. Technol. 2012, 2, 683–693. [Google Scholar] [CrossRef]
- Daksh, D.; Agrawal, Y.K. Rare earth-doped zinc oxide nanostructures: A review. Rev. Nanosci. Nanotechnol. 2016, 5, 1–27. [Google Scholar] [CrossRef]
- Mazierski, P.; Mikolajczyk, A.; Bajorowicz, B.; Malankowska, A.; Zaleska-Medynska, A.; Nadolna, J.J.A.C.B.E. The role of lanthanides in TiO2-based photocatalysis: A review. Appl. Catal. B-Environ. 2018, 233, 301–317. [Google Scholar] [CrossRef]
- Verma, K.; Goyal, N.; Kotnala, R. Lattice defect-formulated ferromagnetism and UV photo-response in pure and Nd, Sm substituted ZnO thin films. Phys. Chem. Chem. Phys. 2019, 21, 12540–12554. [Google Scholar] [CrossRef]
- Vakili, B.; Shahmoradi, B.; Maleki, A.; Safari, M.; Yang, J.; Pawar, R.R.; Lee, S.-M. Synthesis of immobilized cerium doped ZnO nanoparticles through the mild hydrothermal approach and their application in the photodegradation of synthetic wastewater. J. Mol. Liq. 2019, 280, 230–237. [Google Scholar] [CrossRef]
- Yuan, C.; Cui, W.; Sun, Y.; Wang, J.; Chen, R.; Zhang, J.; Zhang, Y.; Dong, F. Inhibition of the toxic byproduct during photocatalytic NO oxidation via La doping in ZnO. Chin. Chem. Lett. 2020, 31, 751–754. [Google Scholar] [CrossRef]
- Munawar, T.; Mukhtar, F.; Nadeem, M.S.; Riaz, M.; ur Rahman, M.N.; Mahmood, K.; Hasan, M.; Arshad, M.; Hussain, F.; Hussain, A. Novel photocatalyst and antibacterial agent; direct dual Z-scheme ZnO–CeO2-Yb2O3 heterostructured nanocomposite. Solid State Sci. 2020, 109, 106446. [Google Scholar] [CrossRef]
- Gutha, Y.; Pathak, J.L.; Zhang, W.; Zhang, Y.; Jiao, X. Antibacterial and wound healing properties of chitosan/poly(vinyl alcohol)/zinc oxide beads (CS/PVA/ZnO). Int. J. Biol. Macromol. 2017, 103, 234–241. [Google Scholar] [CrossRef]
- Bai, H.; Liu, Z.; Sun, D.D. Hierarchical ZnO/Cu “corn-like” materials with high photodegradation and antibacterial capability under visible light. Phys. Chem. Chem. Phys. 2011, 13, 6205–6210. [Google Scholar] [CrossRef]
- Sudheesh Kumar, P.; Lakshmanan, V.-K.; Anilkumar, T.; Ramya, C.; Reshmi, P.; Unnikrishnan, A.; Nair, S.V.; Jayakumar, R. Flexible and microporous chitosan hydrogel/nano ZnO composite bandages for wound dressing: In vitro and in vivo evaluation. Appl. Mater. Interfaces 2012, 4, 2618–2629. [Google Scholar] [CrossRef] [PubMed]
- Sudarshan, N.; Hoover, D.; Knorr, D. Antibacterial action of chitosan. Food Biotechnol. 1992, 6, 257–272. [Google Scholar] [CrossRef]
- Tsai, G.-J.; Su, W.-H. Antibacterial activity of shrimp chitosan against Escherichia coli. J. Food Prot. 1999, 62, 239–243. [Google Scholar] [CrossRef] [PubMed]
- Shin, Y.; Yoo, D.; Jang, J. Molecular weight effect on antimicrobial activity of chitosan treated cotton fabrics. J. Appl. Polym. Sci. 2001, 80, 2495–2501. [Google Scholar] [CrossRef]
- Fei Liu, X.; Lin Guan, Y.; Zhi Yang, D.; Li, Z.; De Yao, K. Antibacterial action of chitosan and carboxymethylated chitosan. J. Appl. Polym. Sci. 2001, 79, 1324–1335. [Google Scholar] [CrossRef]

| Method | Preparation Shape | Advantages | Disadvantages | References |
|---|---|---|---|---|
| Sol–gel | Nanorods; Nanotubes; Nanobelts; Nano springs; Nano spirals; Nano rings. | (1) Uniform doping; (2) High stability; (3) Low synthesis temperature. | (1) Expensive raw material prices; (2) Longer reaction time; (3) Organics escape. | [32,33,34] |
| Co-precipitation | Homogeneous and spherical; Nanobelts; Nano springs. | (1) Simple preparation process; (2) Low cost; (3) Short synthesis cycle. | (1) Additional precipitant; (2) High temperature calcination; (3) Uneven dispersion. | [35,36] |
| Microwaves-assisted | Nanorods; Nanotubes; Nanobelts; Nano springs. | (1) High synthesis efficiency; (2) Energy saving; (3) Improved material properties. | (1) Indeterminate form; (2) Large investment; (3) High requirements for equipment. | [37,38,39] |
| Hydrothermal | Nanobelts; Nano springs; Nano spirals. | (1) Less thermal stress; (2) High particle purity; (3) Controllable crystal shape; (4) Low cost. | (1) Inconvenient to observe; (2) Not intuitive; (3) High equipment requirements; (4) Technical difficulty; (5) Poor safety performance. | [40,41,42] |
| Water Type | Sample Type | Microbial Pollution Target | Types of Adsorbents | References |
|---|---|---|---|---|
| sDrinking water | Domestic drinking water | Bacteria; virus; protozoan; | Activated carbon; | [110] |
| Carbon-graphene; | [111] | |||
| Nano adsorbent; | [112] | |||
| Microbial contaminants. | Carbon-graphene. | [113] | ||
| Drinking water source | Biological contaminants; | Nano adsorbent; | [114] | |
| Microbial contaminants; | Iron Oxide Nanoparticles; | [115] | ||
| E. coli. | Mixed matrix. | [116] | ||
| Wastewater | Lake wastewater | Pathogenic microorganisms. | Zinc oxide; Iron oxide; Silver oxide nanoparticles. | [117,118] |
| Domestic wastewater | Antibiotics; | Biochar; | [119] | |
| Pathogenic microorganism; | Activated carbon; | [120] | ||
| V. fischeri, B. subtilis, E. coli; | Carbon nanotube; | [121] | ||
| Pathogenic microorganism. | Copper oxide; Zinc oxide; Silver oxide; Titanium oxide. | [122,123] | ||
| Industrial wastewater | Pathogenic microorganisms; | Graphene oxide nanosheets; Silver nanoparticles; | [124] | |
| Virus. | Carbon nanotubes; TiO2. | [125] | ||
| Laboratory water | Laboratory simulated water | Enterobacter, Citrobacter, Hafnia; | Biochar stabilized; Iron oxide; Copper oxide nanoparticles; | [126] |
| Klebsiella, Escherichia; | Fe3O4; SnO2; NiO; PAN/boehmite nanofibers. | [127] | ||
| S. aureus, E. coli; | Electro spun; Nanofibers; | [128] | ||
| Bacteria; virus. | Silver @ Eggshell; Nanocomposite. | [83,129] | ||
| Laboratory pure water | S. aureus, E. coli, C. albicans; | Ag nano-embedded pebbles; Nano cellulose; | [85] | |
| E. coli. | Nanofibers; Granular activated carbon; | [130,131] | ||
| Graphite flake. | [132] |
Publisher’s Note: MDPI stays neutral with regard to jurisdictional claims in published maps and institutional affiliations. |
© 2022 by the authors. Licensee MDPI, Basel, Switzerland. This article is an open access article distributed under the terms and conditions of the Creative Commons Attribution (CC BY) license (https://creativecommons.org/licenses/by/4.0/).
Share and Cite
Xin, Z.; He, Q.; Wang, S.; Han, X.; Fu, Z.; Xu, X.; Zhao, X. Recent Progress in ZnO-Based Nanostructures for Photocatalytic Antimicrobial in Water Treatment: A Review. Appl. Sci. 2022, 12, 7910. https://doi.org/10.3390/app12157910
Xin Z, He Q, Wang S, Han X, Fu Z, Xu X, Zhao X. Recent Progress in ZnO-Based Nanostructures for Photocatalytic Antimicrobial in Water Treatment: A Review. Applied Sciences. 2022; 12(15):7910. https://doi.org/10.3390/app12157910
Chicago/Turabian StyleXin, Ziming, Qianqian He, Shuangao Wang, Xiaoyu Han, Zhongtian Fu, Xinxin Xu, and Xin Zhao. 2022. "Recent Progress in ZnO-Based Nanostructures for Photocatalytic Antimicrobial in Water Treatment: A Review" Applied Sciences 12, no. 15: 7910. https://doi.org/10.3390/app12157910
APA StyleXin, Z., He, Q., Wang, S., Han, X., Fu, Z., Xu, X., & Zhao, X. (2022). Recent Progress in ZnO-Based Nanostructures for Photocatalytic Antimicrobial in Water Treatment: A Review. Applied Sciences, 12(15), 7910. https://doi.org/10.3390/app12157910

